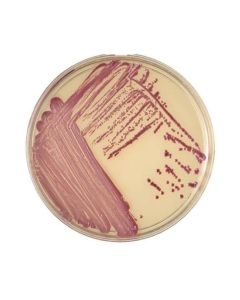
BD BBL CHROMagar MRSA-Plated Media

We use cookies to make your experience better. To comply with the new e-Privacy directive, we need to ask for your consent to set the cookies. Learn more.
BD
-

BD BBL Sensi-Disc antimycobacterial discs
BD BBL Sensi-Disc antimycobacterial discs contain antimycobacterial agents for qualitative susceptibility studies of mycobacteria and related organism...(more info)Starting at $106.04
GROUP SKU: BD-BBL-SENSI-DISC MFG. NAME:" BD -
BD BBL CHROMagar MRSA-Plated Media
BD BBL CHROMagar; MRSA Plate...(more info)Starting at $292.01
GROUP SKU: BD-BBL-CHROMAGAR-PLATEDMEDIA MFG. NAME:" BD -

Patient Room Collectors
BD patient room collectors are available in BD Recykleen brand and BD standard brand, and come in a variety of sizes and colors....(more info)Starting at $90.40
GROUP SKU: BD-PATIENTROOMCOLLECTORS MFG. NAME:" BD -

Chemotherapy Collectors
BD chemotherapy sharps collector, Yellow, Liquid absorbing pad...(more info)Starting at $273.29
GROUP SKU: BD-CHEMOTHERAPYCOLLECTORS MFG. NAME:" BD -

Pharmaceutical Waste Collector
BD pharmaceutical waste collector...(more info)Starting at $295.86
GROUP SKU: BD-PHARMAWASTECOLLECTOR MFG. NAME:" BD -

BD BBL CultureSwab EZ collection
BD BBL CultureSwab EZ collection and transport systems...(more info)Starting at $189.13
GROUP SKU: BD-BBL-CULTURESWAB-EZ MFG. NAME:" BD -

BD BBL Prepared Plated Media
BD BBL prepared plated media enable the isolation of microorganisms from samples or specimens. ...(more info)Starting at $48.67
GROUP SKU: BD-BBL-PLATED MEDIA MFG. NAME:" BD -

BD BBL Gram Stain Kits
BD BBL Gram Stain Kits...(more info)Starting at $182.50
GROUP SKU: BD-BBL-GRAMSTAIN MFG. NAME:" BD -

BD Sureprep Capillary Tubes
BD Sureprep Capillary Tubes...(more info)Starting at $189.13
GROUP SKU: BD-SUREPREP-CAPILLARYTUBES MFG. NAME:" BD -

Conventional Syringes
BD Syringe™ has built a legacy on quality, performance, and consistency, making it the worlds number one selling syringe....(more info)Starting at $120.68
GROUP SKU: BD-CONV-SYRINGES MFG. NAME:" BD
